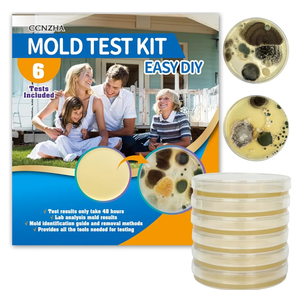
Mold Test Kit for Home -DIY Mold Testing Kit with 6 Individual Tests-Black Mold Detector-Indoor Air Quality Tester-Mold Identification Guide-Free Lab Analysis-Fast and Reliable Mold Detector at Home

Professional OBD2 Breakout Box with LED Indicator, 16-Pin OBD2 Diagnostic Tool Automotive Electrical Tester Portable Auto OBD2 Protocol Detector Monitor Car Testing
Condition: Appears New
Pickup Details
| Saturday, Feb 7 | 08:30AM - 02:00PM |
| Monday, Feb 9 | 11:00AM - 06:30PM (Appointment only) |
| Tuesday, Feb 10 | 12:00PM - 06:30PM |
| Wednesday, Feb 11 | 11:00AM - 06:30PM (Appointment only) |
Product Details
| SKU | OLARR6152201 |
| ASIN | B0DZ78J8BY |